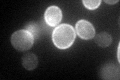
YLR237W
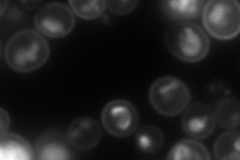
YLR237W
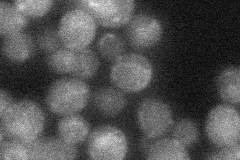
YLR237W
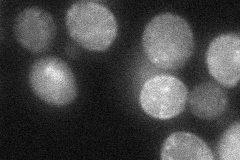
YLR237W
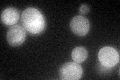
YLR237W
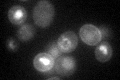
YLR237W

View description
Plasma membrane transporter responsible for the uptake of thiamine, member of the major facilitator superfamily of transporters; mutation of human ortholog causes thiamine-responsive megaloblastic anemia
Localization:
Intensity:
Fold change:
Significance:
-
C’ GFP library in SD
cell periphery47.61 -
N' NOP1pr-GFP in SD

cell periphery,ER113.63 -
N' TEF2pr-mCherry in SD
cell periphery,vacuole159.878 -
N' NATIVEpr-GFP in SD
cell periphery29.0399 -
N' TEF2pr-VC and Cyto-VN in SD
cell periphery,punctate38.8147 -
C’ GFP library in SD+DTT
cell periphery28.790.6Yes -
C’ GFP library in SD+H2O2

punctateN/AN/ANo -
C’ GFP library in Starvation Media

cell periphery17.480.36Yes -
C’ GFP library on the background of Pup2-DaMP
vacuole, cell periphery -
C’ GFP library on the background of CCT mutant

cell periphery36.87570.7744No
